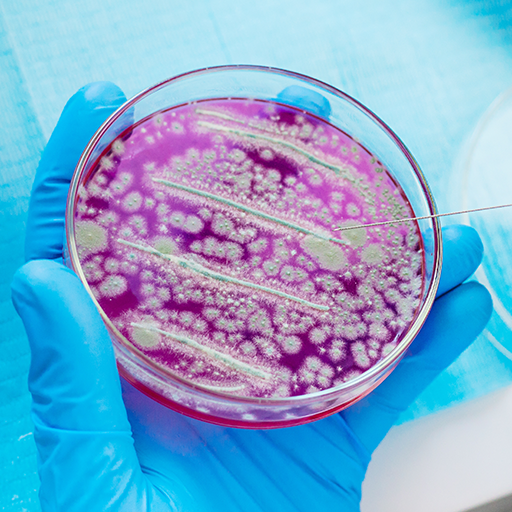

Članki >> NARAVNO ZDRAVJE >> RASTLINSKA FORMULA ZA PREBAVNE TEŽAVE …
Rastlinska formula za prebavne težave – zaprtje, napihnjenost, plini IZGINEJO ŽE OD 1. DOZE

Strokovnjaki opozarjajo: težave z iztrebljanjem lahko resno ogrožajo zdravje!
Zadnja zdravstvena poročila kažejo, da se več kot polovica Slovencev sooča z zaprtjem in težavami črevesja. Ne le, da zmanjšujejo kakovost življenja, ampak predstavljajo tudi zdravstveno tveganje in lahko vodijo do številnih posledic: hemoroidov, vnetij in v skrajnih primerih celo raka črevesja. Priljubljeni čaji, odvajala in domača sredstva v praksi le poslabšajo težavo. Kako torej učinkovito odpraviti prebavne težave in preprečiti nevarne posledice?
Zakaj zaprtje resnično ogroža zdravje? Pojasnjuje prof. Manja Zavodnik

Veliko ljudi se sramuje priznati, vendar je zaprtje zelo pogosta težava. Ob tem se pojavljajo boleči krči v trebuhu, občutek teže ter neprijetna napihnjenost in plini. To prizadene več kot 50 % ljudi v Sloveniji. Ostanki hrane, ki ostajajo v črevesju, fermentirajo in gnijejo, kar povzroča, da se toksini sproščajo v krvni obtok in zastrupljajo organizem. To povzroča slabše počutje, glavobole, slab zadah, alergije in druge težave. In to je šele vrh ledene gore! Zaprtje upočasni metabolizem, kar vodi do težav pri izgubi odvečne teže. Dolgotrajno zanemarjanje simptomov lahko povzroči krvavitve iz danke, hemoroide, vnetja črevesja in celo raka prebavil …
Čaji in odvajala – ali res poslabšajo prebavne težave?
ajpogosteje poskušajo osebe z zaprtjem težave reševati z običajnimi sredstvi – suhe slive, infuzije iz sene, zeliščne tablete. Njihov učinek temelji na sprostitvi blata in povzročanju odvajanja. Učinek je hiter, a začasen. Pogosta uporaba teh metod le poslabša težave, saj se zaprtje, napihnjenost in krči vrnejo močnejši kot prej. To je zato, odvajala dražijo in uspavajo črevesje, kar vodi v izgubo mišičnega tonusa in skoraj popolno okvaro delovanja črevesja. Namesto olajšanja čutimo, da se zaprtje poslabša – trebušne težave, napihnjenost in plini postanejo še bolj nadležni.
Opazite pri sebi katerega od teh simptomov?

Se sliši znano? Ne čakajte, da se vaše zdravje poslabša. Obnovite pravilno prebavo, regenerirajte črevesje in se zaščitite pred zapleti.
Kako hitro in učinkovito odpraviti zaprtje in izboljšati prebavo?
Svojim varovancem odločno odsvetujem dolgotrajno uporabo čajev in odvajal. Namesto tega priporočam inovativen, organski pripravek proti zaprtju. Razvil ga je Norveški inštitut za zdravo prehrano kot varno alternativo neučinkovitim in tveganim odvajalom. Vsebuje bioaktivne sestavine, ki na popolnoma varen način povrnejo naravni ritem iztrebljanja. Težavo z zaprtjem rešuje celovito, saj deluje na 3 različnih ravneh:
S pomočjo izvlečka benediktinke regenerira jetra in spodbuja izločanje žolča. Obnavlja mišični tonus črevesja in optimizira njegovo delovanje. Obenem regenerira poškodovano sluznico in ustvarja zaščitni sloj na črevesnih stenah. Z izvlečkom acai palme pozitivno vpliva na sluznice in obnavlja naravni črevesni mikrobiom, kar normalizira peristaltiko. Hrana se premika gladko in brez težav, kar omogoča enostavno in neboleče iztrebljanje. Pospešuje presnovo in olajša izgubo odvečnih kilogramov.
Zaradi sposobnosti vezave molekul sprošča blato in ga zmehča. Poleg tega izvleček indijske fige izboljša delovanje trebušne slinavke in podpira vsakodnevno iztrebljanje.

Takšna kompleksna kombinacija treh ravni delovanja omogoča trajno odpravo zaprtja, napihnjenosti in krčev – brez diet, spremembe življenjskega sloga ali neželenih učinkov
Priljubljena odvajala agresivno vplivajo na prebavni sistem in težav ne rešujejo, temveč jih poslabšajo. Inovativni tretma 100 % naravno spodbuja črevesje, olajša premikanje hrane in sprošča blato. Zahvaljujoč trojnemu učinku učinkovito odstrani zaprtje že po prvi uporabi, hkrati odpravi napihnjenost in pline ter ublaži trebušne bolečine, krče in kolike. Odstrani toksine in usedline iz črevesja, izboljša počutje, odpravi glavobole, kronično utrujenost, alergije in številne druge težave.
Revolucionarni tretma 100 % naravno, varno in trajno:

odpravi kolike in trebušne bolečine – v 60 minut

obnavlja črevesno floro – v 2 dneh

odpravlja zaprtje – v 24 urah

odstrani napihnjenost in pline – v 15 minutah

očisti toksine iz črevesja – v 48 urah

vzpostavi redno iztrebljanje – v 7 dneh

normalizira presnovo – v 4 dneh

poveča peristaltiko črevesja za 84 % – v 7 dneh

Nov, naravni tretma proti zaprtju in prebavnim težavam je od zdaj na voljo tudi v Sloveniji.

Prijetno presenečenje – izgubila sem 7,5 kg!
„Zaradi črevesnih težav sem se bala normalno jesti. Kefirji, čaji, jogurti – nič ni delovalo. Po vsakem obroku sem bila napihnjena in otečena, bilo je le še slabše in slabše. Bala sem se že, da je kaj resnega! Šele ta kura je resnično pomagala. Vzela sem jo in zaprtje je takoj minilo. Moj metabolizem je končno stekel, ker se je črevesje očistilo. In nisem pričakovala, a shujšala sem 7,5 kg v enem mesecu! Počutim se lahkotno in fit!”
Barbara K. (47 let)
Trebnje

Mučenje na WC je preteklost
„Nekoč je bil vsak obisk stranišča muka. Nato mi je prijateljica priporočila ta naravni tretma. Dovolj je bilo nekaj minut in napihnjenost, brnenje in krči v trebuhu so izginili. Potem je šlo vse gladko in zaprtje je izginilo za vedno. Pozabila sem na te muke na stranišču, grozne pline in trebušne bolečine, poleg tega je moja polt bolj sijoča.”
Ines P. (65 let)
Pivka

Končno lahko priporočim nekaj, kar deluje
„Pri močnejšem zaprtju sem lahko celo teden dni nisem mogel opraviti potrebe. To je bil pekel. Bolečine, napihnjen trebuh – vsak ve, kako je … Poskusil sem marsikaj, da bi si olajšal. Dokler ni prišlo do tega, da brez odvajal sploh ni bilo nič. Hči mi je zrihtala ta tretma in vse se je uredilo. Kot da bi mi črevesje popravili! Vse druge preparate sem vrgel stran. Priporočam iskreno, ker res deluje.”
Henrik V. (70 let)
Velenje
Inovativni rastlinski tretma proti zaprtju, ki ga je razvil Norveški inštitut za zdravo prehrano
Ta naravni tretma je varna alternativa za neučinkovita in škodljiva odvajala.
Vsebuje bioaktivne sestavine, ki varno in nežno obnavljajo naravni ritem iztrebljanja. Omogoča hitro in enostavno odpravo trdovratnega zaprtja, ki zastruplja telo. Kako deluje ta inovativni tretma?

Aktivira naravno delovanje črevesja
Bioaktivne snovi oskrbujejo celice črevesnega epitelija z energijo, spodbujajo naravno aktivnost in podpirajo pravilno peristaltiko ter prebavo.
Deluje že od 1. doze
Že 1 doza tretmaja učinkovito odpravi zaprtje in prebavne težave s pomočjo trojnega mehanizma delovanja: izboljšava mišične napetosti, regeneracija sluznice in zmehčanje blata.
Olajša učinkovito iztrebljanje
Tretma stimulira vlažnost sluznice črevesja, s tem pa se hrana premika tekoče in brez ovir, to pa zelo olajša iztrebljanje.
Odpravlja kolike, napihnjenost, pline
Formula hitro odstrani neprijetne simptome, ki spremljajo prebavne težave. Nelagodje med prebavo izgine, vi pa končno začutite olajšanje in lahkoten občutek po hrani.
Čisti toksine in usedline iz črevesja
Ravno usedline toksinov v črevesju povzročajo občutek utrujenosti, težkosti in prebavnih težav. Lahko imajo celo 20 kg! Formula učinkovito odstrani strupene usedline iz telesa, s tem pa izginejo težave, kot so glavobol, bolečine v trebuhu, težave s prebavo in kronična utrujenost.
Podpira hujšanje
Zaradi čiščenja črevesje začne ponovno pravilno funkcionirati, metabolizem pospeši z vrtoglavo hitrostjo, posledično pa odvečni kilogrami dobesedno sami izginejo. Brez diet in učinka yo-yo!
Ne draži črevesja
Za razliko od agresivnih sredstev za čiščenje, ki delujejo dražilno na prebavo in oslabijo črevesje, ta tretma nežno in naravno regenerira sluznico in stene črevesja.
Ščiti pred zapleti
Ta naravni pripravek ne le odpravlja zaprtje, temveč deluje tudi preventivno proti njegovim značilnim posledicam. Pomaga preprečevati razvoj vnetij ter nastanek nevarnih črevesnih zapor in hemoroidov, s čimer povrne naravno prebavno ravnovesje.

Levo: črevesje blokirano z usedlinami, ki otežujejo iztrebljanje
Desno: pravilno delujoče črevesje.
O črevesju pravijo, da je naš drugi možgan. V njem je kar 100 milijonov živčnih celic! Njegovo pravilno delovanje neposredno vpliva na vaše počutje in razpoloženje. A ali ste vedeli, da je v vašem črevesju lahko do 20 kg usedlin?! Če jih odstranite, se znebite tudi zaprtja, napihnjenosti, plinov in trdovratne prekomerne teže! Očistite toksine iz telesa, ki vas zastrupljajo od znotraj, povzročajo glavobole, slabo počutje in zdravstvene težave. Končajte z boleznijo, okrepite imunski sistem in začutite val energije!

OD UREDNIŠTVA: Naravna kura proti zaprtju in prebavnim težavam je pravkar prišla v uradno distribucijo na slovenski trg. Prvih 100 oseb, ki jo potrebujejo, lahko prejme pakiranje kure za simbolični znesek 1 EUR!
Kliknite, da preverite razpoložljivost promocijskih pakiranj kure >>>>
KOMENTARJI:
Preberite komentarje za članek „Rastlinska formula za prebavne težave…”


Petra_89
Res sem imela dovolj. Zaradi zaprtja nobena dieta ni delovala. Stradala sem, a teža se ni premaknila. Ni čudno, če ves čas nosiš toliko v črevesju. Tudi ne želim razmišljati, kaj vse je bilo v meni. Zdaj se ne le počutim bolje, ampak sem celo kupila manjše hlače. Teža še naprej pada.

Pero
Poslušajte ljudje, povem vam eno ... ta odvajala so zlo! Ali letaš na stranišče non stop ali pa, ko nehaš jemati, sam ne moreš več na potrebo. Resno sem si s tem škodoval! Šele kolegica mi je priporočila ta naravni pripravek. In zdaj končno vse deluje, kot mora.

Janina_444
Nisem več vedela, kaj jesti, da bi zaprtje minilo… Lanena semena, kefir in ne vem kaj še. Včasih sem jedla samo sadje, da ne bi bilo slabše. Od tega je bil trebuh kot balon! Nobenega veselja od hrane … Nobenih sladkarij, nič okusnega. Še žemlje sem morala nehati jesti. Imela sem dovolj! Hči mi je dala ta tretma, ker je imela podoben problem. Jemljem in hvala Bogu, da nekaj končno pomaga!

Jerneja_LP
Sploh nisem verjela v te tablete. In da delujejo takoj – sploh ne. Preizkusila sem že preveč stvari v življenju. Tukaj sem bila presenečena. Vzela zvečer, zjutraj pred službo sem normalno šla na stranišče. Skoraj sem pozabila, kako je če nimaš zaprtja.

Miha_CC
In veste, kaj je bilo najslabše? Ti stalni plini … Ves čas sem jih spuščal. Sram me je bilo iti ven! Napet trebuh, kruljenje in plini… Ampak to se je končalo. Po tem tretmaju nič več ne fermentira, ker se nič ne več ne odlaga in končno lahko živim kot človek.

Martin_L
Hotel sem malo poskrbeti za sebe, zato sem prenehal kaditi. Rezultat pa je bil tak, da se je metabolizem ustavil in sem se zredil. In res nisem jedel prigrizkov! Mama mi je dala ta tretma, ker ga je sama jemala za zaprtje. In takoj je bilo bolje. Hitro sem shujšal te kilograme in potem teža ni več norela.

Erika
Imela sem razjede v črevesju – vse se je tam izsušilo. Zaprtje plus razjede, pa še stalna vnetja črevesja. Groza! Dobro, da je ta preparat pomagal, sicer pa sem to pričakovala, ker narava vendar mora delovati.

Mare214
Kot da ni pomembnejših problemov kot to, da se kdo ne more usr… oprostite, iztrebljati. Ukvarjajte se z nečim smiselnejšim, ljudje…

Kristina Novak
@Mare214 Eh, lahko ti je govoriti, če pa o tem ne veš nič!! Preberi nekaj o tem! Veš, da se lahko ta na videz majhen problem spremeni v resnega?!!! Tudi v bolezen? Kljub temu pa želim zdravje…

Ana Šeško
Super, da končno nekaj učinkovitega in še skoraj zastonj. Ravno to je manjkalo na trgu.
Kliknite, da preverite razpoložljivost promocijskih pakiranj kure >>>>

Anita
Super, da lahko zdaj vse hitro uredim. Enkrat zjutraj in zadeva je rešena. Pred tem je bil to pravi horor. Napihnjenost, brnenje, pol ure sedenja brez učinka… In to večkrat na dan. Fantastično!!!!